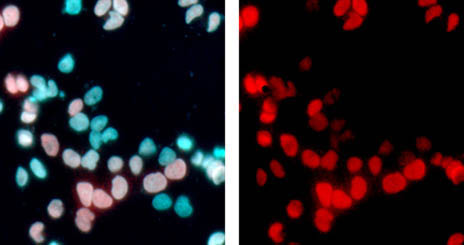

Un trabajo de investigación, llevado a cabo en el laboratorio de Oncología de la Unidad de Medicina Molecular del Centro Regional de Investigaciones Biomédicas –CRIB-, de la Universidad de Castilla-La Mancha (UCLM), abre nuevos caminos sobre el uso de genes virales como supresores de tumores. Tal es el caso del gen E1a de adenovirus, que ha sido capaz de bloquear la aparición de tumores en animales expuestos a carcinógenos en su piel. El estudio, dirigido por el investigador del Programa Increcyt, Ricardo Sánchez Prieto, se acaba de publicar en la prestigiosa revista «Cancer letters» (número 23 de las 213 de oncología, según el Journal Citation Report).
Este trabajo de investigación, explica Ricardo Sánchez, se ha centrado en estudiar el efecto del gen E1a de adenovirus en distintos tipos de tumores. Para ello, se diseñó un sistema de transgénesis que permite la expresión controlada de este gen por los investigadores, tanto en el tiempo como en el tejido elegido. “Los resultados demuestran que E1a fue capaz de bloquear la aparición de tumores en animales expuestos a carcinógenos en su piel y, aún más, líneas celulares derivadas de tumores humanos de colon o melanoma, en los que se introdujo la expresión de E1a mediante técnicas de ingeniería genética, fueron incapaces de generar tumores en animales inmunodeprimidos”, señala.
[ze_summary text=»El gen fue capaz de bloquear la aparición de tumores en animales expuestos a carcinógenos en su piel»]El gen fue capaz de bloquear la aparición de tumores en animales expuestos a carcinógenos en su piel[/ze_summary]
Este trabajo, parte central de la tesis de Francisco Jose Cimas Felipe, becario predoctoral de la Fundación Leticia Castillejo Castillo, “supone una prueba clave para el uso de esta prometedora terapia basada en adenovirus”, afirma el investigador. En dicha investigación han participado todos los miembros del laboratorio de Oncología, junto con el equipo del doctor Santiago Ramón y Cajal (Hospital Vall d’Hebron de Barcelona), el doctor Silvio Gutkind (Moore Cancer Center, Universidad de San Diego, California) y la doctora Dolores García Olmo (Complejo Hospitalario Universitario de Albacete).
El gen E1a, explica Ricardo Sánchez, es uno de los genes clave en el ciclo vital de los adenovirus, “que son los vectores por excelencia para una de las terapias más novedosas en cáncer en la actualidad, como son los virus oncolíticos”.
El laboratorio de Oncología de la Unidad de Medicina Molecular del CRIB, sitúa a Castilla-La Mancha a la vanguardia de la investigación oncológica durante los últimos 12 años, como lo refleja las más de 35 publicaciones en prestigiosas revistas internacionales especializadas, la realización de ocho tesis doctorales y cinco más en ejecución, además de cuatro proyectos nacionales consecutivos, autonómicos y privados con una cuantía de más de 1.500.000 de euros.